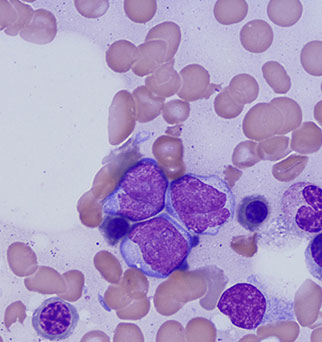

CONOCE QUÉ TIPO DE CITOLOGÍAS INTERPRETARÁN NUESTROS DIFERENTES CITÓLOGOS

Domingo
Roa
Será el encargado de Interpretar todas las muestras de Citologías de Ganglios Linfáticos. Asimismo interpretará Muestras Citológicas de Órganos y Derrames de Cavidades Corporales.

CITOLOGÍAS DE GANGLIOS
CITOLOGÍAS DE GANGLIOS

CITOLOGÍAS DE ÓRGANOS
CITOLOGÍAS DE ÓRGANOS

CITOLOGÍAS DE DERRAMES
CITOLOGÍAS DE DERRAMES

Fernández
Algarra
Será la encargada de Interpretar todas las muestras de Citologías Hematológicas y de Médula Ósea. Asimismo interpretará Muestras de Órganos y Fluidos Corporales.
CITOLOGÍAS HEMATOLÓGICAS
CITOLOGÍAS HEMATOLÓGICAS

CITOLOGÍAS DE MÉDULA ÓSEA
CITOLOGÍAS DE MÉDULA ÓSEA

CITOLOGÍAS DE ÓRGANOS
CITOLOGÍAS DE ÓRGANOS

Albanese
Será el encargado de Interpretar todas las muestras de Citologías Dermatológicas con Exclusividad en España con Nuestro Servicio de Telediagnóstico Citológico.

CITOLOGÍAS DERMATOLÓGICAS
CITOLOGÍAS DERMATOLÓGICAS


 Log in
Log in
